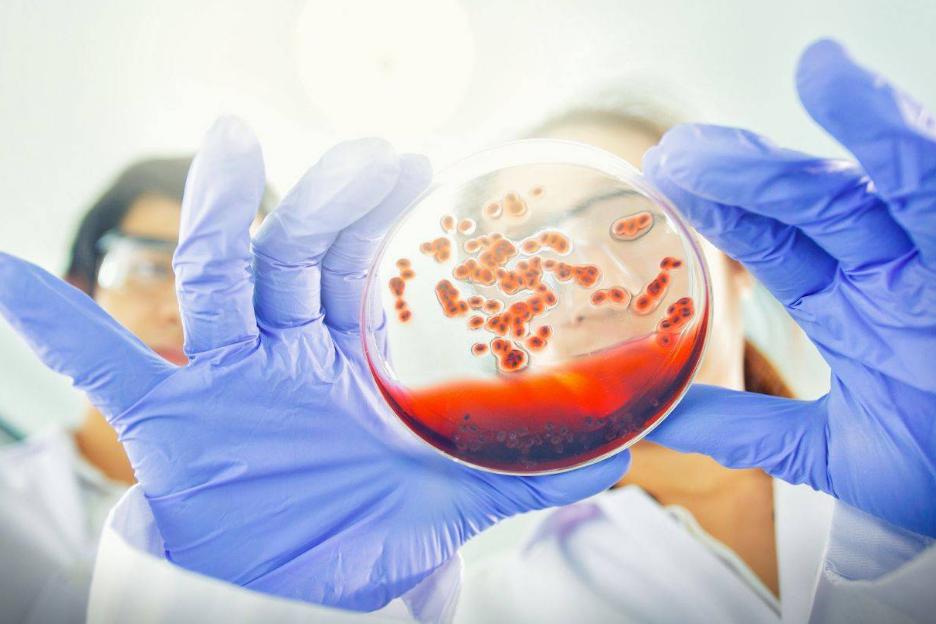
艾滋病别误以为是皮肤病,不要把艾滋病当成皮肤病

年轻人得艾滋病的概率越来越高了,但人们仍然对此保持着无所谓的态度。每一处都张贴的艾滋病宣传海报,每一天都在举行的艾滋病宣讲,让越来越多人以为艾滋病只是身边经常被提起的普通慢性病。
但是大家忽略了艾滋病是一种没有任何解药,全球自愈案例不超过两三例,上千万人只剩五到十年生命的一种可怕疾病。
为什么艾滋病需要人们如此小心?因为艾滋病作为世界范围内都难以攻克的难题,一旦感染,几乎没办法治愈。
而导致艾滋病几乎没法治愈的原因就在于——艾滋病毒具有很强的“隐蔽性”,其突变能力非常强,在加上病毒对免疫系统的攻击力很强,导致了不能大范围治愈的局面。
那么对于随处可见的艾滋病,你到底知道多少?

一、注意!别把艾滋病当皮肤病,这些症状或许就是信号
众所周知,艾滋病是具有传染性的疾病,医学上将艾滋病分为四个阶段:窗口期、潜伏期、艾滋病前期、典型艾滋病期。
最关键的是艾滋病具有有潜伏期,这个阶段并不会当场给人警示,一些并不起眼的症状经常会被人们忽视,最终导致艾滋病毒的飞速传播。为了避免亲人朋友无辜的人受到伤害,在这些症状出现时,就要提高警惕。
1.感冒症状出现
首先,艾滋病感染者在感染前期会有类似于感冒的症状出现,这是艾滋病毒攻破我们身体防线的第一步。
艾滋病前期感冒症状会有包括流鼻涕、鼻塞、喉咙痛等症状并伴有全身无力腰背四肢酸痛的情况出现。

再严重的患者就会有发烧的现象。全身持续的低烧就是前期最常见的症状。如果在服用发烧感冒类药品后没有好转,就需要警惕艾滋病的传染。
其次,艾滋病从感染到发病有着很长的一段间隙,口腔溃疡也是典型表现之一。大多数患者会出现口腔症状,例如口腔中出现毛状白斑,突发牙周病、以及长出一个或多个肉瘤等。
艾滋病毒会影响人的免疫力,从而使人的身体变得虚弱,各种病毒乘虚而入。随着病毒的进一步发展,艾滋病毒还会对全身的细胞造成影响。肌肉酸痛、头晕头痛、恶心想吐等症状也会发生。
一旦病毒开始侵犯人体内部器官,就会出现持续性发热,咳嗽,呼吸困难等症状。

2.淋巴结肿大
当身体的免疫系统被侵犯,许多艾滋病患者被病毒攻击的表现之一就是浅表淋巴结肿大,大多发生在头颈部、耳前、头颈部、股淋巴结、颌下淋巴结等。
通俗来说就是我们的腋窝等部位出现红肿,发炎等现象,一般至少有两处以上的部位肿大,且直径超过1cm,坚硬不痛还可移动,持续超过三个月就需要及时去医院检查。
3.皮肤损伤
皮肤黏膜是艾滋病毒主要侵入的人体部位之一,很多艾滋病患者都是以皮肤损害为艾滋病初期的症状。多表现为唇疱疹和皮疹。
在机体免疫力下降的同时还会出现鹅口疮的症状,临床表现为口腔黏膜上附着着灰白色的薄膜,边界清晰,周围有红晕,假膜刮去可出现红色湿润面。

很多人认为这是皮肤病的症状,随意买一些药品涂抹。但是会发现药物并不能使状况缓解,甚至于随着时间的发展越来越严重。因为,在发现这样的现象后,及时就医才是最重要的。
二、别小看艾滋病!这些传播方式,你可能不知道!
为什么人们日常生活中处处可见艾滋病的宣传,但是对于艾滋病的了解仅仅是“男同病”这种表面的解释呢?
因为艾滋病的传播途径非常的明确只有性传播、血液传播和母婴传播三种传播方式。研究表明我们与艾滋病患者吃饭聊天甚至于拥抱都不会被传染,这就是人们小看艾滋病的原因。
但是生活中有着许多我们无法预料和忽视的小细节,这都是我们会离死神更近一步的行为。如何在生活中保护自身健康,预防艾滋病,下面将从艾滋病传播的三个途径一一为大家讲述。

1.性传播
湖南长沙,某女子早前被确诊患有HIV阳性,且一直在医院进行治疗并领取药物。2022年9月,该女子在自己的出租屋内实施了卖淫嫖娼活动,并未告知嫖娼男子,在无任何措施的情况下与对方发生性关系,导致男子感染上艾滋病毒。
通过案例,大家可以很清晰地发现案例中的艾滋病毒就是通过*行为性**进行传播。
性传播是艾滋病传播的重要途径之一,在发生*行为性**时,患者体内会分泌很多体液,其中携带了大量的艾滋病毒,病毒在进入对方身体内,则对方会被病毒感染从而成为艾滋病患者。
所以,不管是男性还是女性,保持健康的*生活性**是避免患上艾滋病的重要措施。

不要与不明健康状况的人发生性关系,在*生活性**的同时一定要戴上安全套。使用安全套能大幅度降低被感染的风险。但是安全套并不能100%规避,所以,洁身自好才能保证自身安全不受侵害。
2.血液传播
某地一男子,被诊断为艾滋病,产生报复社会心理,在公交地铁等人流量大的地方,利用针管注射将自己的血液注射进他人的身体,从而使他们感染艾滋病毒。
为什么该男子想要通过血液和针管传播艾滋病毒呢?
因为血液传播也是艾滋病传播的另一个重要途径。患者血液中含有大量病毒,如果输入或注射含有艾滋病病毒的血液,受血者将会被感染。

在以下的情境中,存在感染艾滋病的风险:
临床所使用的血液均需要经过艾滋病病毒抗体检测,合格后才可使用。输血和献血都应该到正规的地方进行。
注射针头进行消毒以及一人一针一管的措施,不随便与他人共用注射器,是预防疾病的关键。
其他器械以及生活用品的规范。剃须刀修眉刀纹身用品等尖锐物品在使用过程中难免对皮肤带来刺激,使用频率高,用法不恰当,很有可能导致局部出血从而感染。该类物品都要严格按照工序进行消毒措施方可使用。
3.母婴传播
母婴传播是指如果母亲感染了艾滋病毒,在分娩的前中后期均有可能将病毒传染给婴儿。导致另一个不幸的人生。这就告诉了准备孕育生命的家庭,一定要注意做好产前体检,不要觉得麻烦而不去做,这是对下一代的负责。
三、艾滋病“后悔药”你知道吗?
研究表明,1542位被调查的人员中,在回答发生高危行为后或怀疑自己可能被传染艾滋病所做的行为选择,9.14%选择自行查阅资料或去小诊所开药,4.28%选择不就医。
下面就和大家谈一谈发生高危行为后,我们可以拥有哪些“后悔药”?
首先,在24小时范围内,可以及时服用HIV阻断药。恩曲他滨替诺福韦片和拉替拉韦钾片,都是《中国艾滋病诊疗指南》所推荐的药品。可以在当地疾控中心或医院感染科进行购买。
但值得注意的是,服用药物的最佳时期在2小时内,最迟不超过72小时,且需要连续服用28天。

其次,在3个月范围内,我们可以去医院进行检测。选择正规医院的感染科挂证,与医生陈述高危接触史后,按照医生的化验要求进行样本采集,如抽血、口腔拭子、精液阴道分泌物等,通过医学手段筛查样本中是否存在艾滋病毒抗体。
在相同时间期限内,如果对医院检查有排斥心理的同样也可以选择居家自测。居家自测的艾滋病检测试纸一般分为两种:唾液试纸和血检试纸。
艾滋病的潜伏期很长,通常可以达到7~10年,很多人并不知道自己感染,等到发病就医时,往往错过了最佳治疗时期,医生也常常无力回天,检测是知晓艾滋病感染的唯一途径。
需要注意的是去医院进行检测的准确率比试纸检测的准确率高,一般核酸检测经过两次检查显示阳性即可以确诊感染艾滋病。

所以对于艾滋病知识的了解我们需要牢记在心,这不单单是为了自身安全,更是为了亲人、朋友、我们的祖祖辈辈。
参考资料:
1.安骏腾,赵娜,王雅钗,王庆谊,郭雯,李倩男.以红皮病为首发症状的艾滋病一例【J】.中国麻风皮肤病杂志.2022(12):893-894
2.吴涛.身体出现这些症状,当心感染了艾滋病【J】.家庭医药.快乐养生.2021(10):37
3.胡朝军.了解艾滋病传播途径,阻断病毒传播【J】.幸福家庭.2020(07):91
4.陆云,张东杰,师鑫浦,刘艳,李文明.“后疫情时期”男同性恋人群艾滋病防治认知与行为研究【J】.大理大学学报.2022(02):88-93